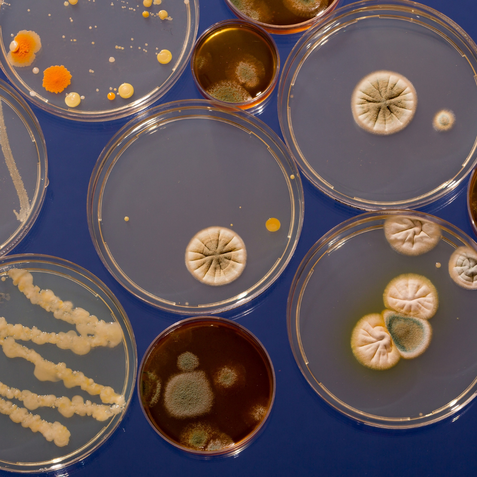

In unserer westlichen Welt gilt Urlaub oft als „Pause von der Arbeit“ oder „Zeit für Reisen“. Aus der Sicht der Traditionellen Chinesischen Medizin (TCM) hat Urlaub jedoch eine viel tiefere Bedeutung. Er ist nicht nur Erholung, sondern eine bewusste Möglichkeit, Qi (Lebensenergie) zu regenerieren, Yin und Yang auszugleichen und die Organe zu stärken.

Erfahren Sie, wie Breuss-Massage, Bachblüten, Ohrkerzen und Gemmotherapie Körper, Geist und Seele stärken können.
Ganzheitliche Naturheilkunde für Entspannung, Heilung und innere Balance.
Ganzheitliche Naturheilkunde für Entspannung, Heilung und innere Balance.

In der modernen Medizin werden Wunden nach ihrer Dauer und Heilungsfähigkeit unterschieden:
Akute Wunden: Heilen in einem erwartbaren Zeitraum von 2–4 Wochen.
Chronische Wunden: Persistieren länger als 6–8 Wochen oder treten rezidivierend auf (z. B. diabetisches Fußsyndrom, Ulcus cruris, Dekubitus).
Die Traditionelle Chinesische Medizin (TCM) geht über die rein lokale Betrachtung hinaus. Wunden sind Ausdruck einer Disharmonie im gesamten Organismus, die über den Fluss von Qi (Lebensenergie), Blut (Xue), Yin/Yang und den Zang-Fu-Organen gesteuert wird.

Warum gesunder Schlaf heute so wichtig ist
Schlafstörungen zählen zu den häufigsten gesundheitlichen Problemen unserer Zeit. Studien zeigen, dass rund ein Drittel der Erwachsenen regelmäßig unter Ein- und Durchschlafproblemen leidet. Die Folgen sind nicht nur Müdigkeit und Konzentrationsschwäche – auch das Immunsystem, die Hormonbalance und die psychische Stabilität leiden.
Schlafstörungen zählen zu den häufigsten gesundheitlichen Problemen unserer Zeit. Studien zeigen, dass rund ein Drittel der Erwachsenen regelmäßig unter Ein- und Durchschlafproblemen leidet. Die Folgen sind nicht nur Müdigkeit und Konzentrationsschwäche – auch das Immunsystem, die Hormonbalance und die psychische Stabilität leiden.

Der Alterungsprozess ist unaufhaltsam, aber gestaltbar. Wer rechtzeitig beginnt, seinen Lebensstil, seine Ernährung, sein Bewusstsein und seine Energie in Balance zu bringen, kann auch im höheren Alter gesund, beweglich, geistig fit und innerlich zufrieden leben.
Altern wird so nicht als Verfall erlebt, sondern als neue Lebensphase mit eigenen Qualitäten und Chancen. Die Verbindung von Naturheilkunde und TCM bietet dabei ein einzigartiges, sanftes Instrumentarium zur Gesundheitsförderung.
Altern wird so nicht als Verfall erlebt, sondern als neue Lebensphase mit eigenen Qualitäten und Chancen. Die Verbindung von Naturheilkunde und TCM bietet dabei ein einzigartiges, sanftes Instrumentarium zur Gesundheitsförderung.

Die Einbettung des weiblichen Zyklus in die fünf Wandlungsphasen der Traditionellen Chinesischen Medizin (TCM) bietet eine tiefgreifende Möglichkeit, hormonelle und energetische Veränderungen im Monatszyklus im Einklang mit der Natur zu verstehen. Die fünf Wandlungsphasen (Holz, Feuer, Erde, Metall, Wasser) beschreiben nicht nur Naturphänomene, sondern auch innere Prozesse im Körper – einschließlich des Menstruationszyklus.

Tinnitus – das ständige Rauschen, Pfeifen oder Summen im Ohr – betrifft nach aktuellen Schätzungen etwa 15–20 % der Bevölkerung in Deutschland. Für viele ist es eine quälende Dauerbelastung. Medizinisch gilt er oft als "nicht heilbar", vor allem bei chronischem Verlauf.
Doch Naturheilkunde und TCM (Traditionelle Chinesische Medizin) bieten einen völlig anderen Zugang: Statt den Tinnitus als isoliertes Ohrproblem zu betrachten, wird er als Symptom einer tiefer liegenden Disharmonie im Körper-Geist-System verstanden – und entsprechend ganzheitlich behandelt.
Doch Naturheilkunde und TCM (Traditionelle Chinesische Medizin) bieten einen völlig anderen Zugang: Statt den Tinnitus als isoliertes Ohrproblem zu betrachten, wird er als Symptom einer tiefer liegenden Disharmonie im Körper-Geist-System verstanden – und entsprechend ganzheitlich behandelt.
Die Blasenentzündung (Zystitis) ist eine der häufigsten bakteriellen Infektionen im urogenitalen Bereich – insbesondere bei Frauen, bei denen die kürzere Harnröhre das Eindringen von Keimen erleichtert. Viele Patient:innen erleben mehrfach im Jahr Beschwerden, die mit der konventionellen Behandlung kaum langfristig in den Griff zu bekommen sind.
Die Traditionelle Chinesische Medizin (TCM) bietet mit ihrem jahrtausendealten Wissen eine differenzierte, ganzheitliche Sicht auf Erkrankungen wie die Zystitis – mit dem Ziel, nicht nur Symptome zu behandeln, sondern das innere Gleichgewicht wiederherzustellen und Rückfälle zu verhindern.
Die Traditionelle Chinesische Medizin (TCM) bietet mit ihrem jahrtausendealten Wissen eine differenzierte, ganzheitliche Sicht auf Erkrankungen wie die Zystitis – mit dem Ziel, nicht nur Symptome zu behandeln, sondern das innere Gleichgewicht wiederherzustellen und Rückfälle zu verhindern.

Migräne ist mehr als nur ein Kopfschmerz – sie ist ein komplexes Geschehen im gesamten Organismus, das auf vielfältige Ursachen zurückzuführen sein kann. In der ganzheitlichen Medizin, insbesondere in der Traditionellen Chinesischen Medizin (TCM), wird Migräne nicht als isoliertes Symptom betrachtet, sondern als Ausdruck eines inneren Ungleichgewichts, das Körper, Geist und Emotionen betrifft. Die genaue Ursache kann individuell sehr unterschiedlich sein – und entsprechend sollte auch die Behandlung individuell abgestimmt werden.

Der Mann zwischen Kraft und Belastung
Männer stehen oft unter besonderem gesellschaftlichen Druck. Beruflicher Erfolg, Familie, Fitness – viele Aufgaben, die mit Energie und Durchhaltevermögen verbunden sind. Doch wenn Symptome wie Erschöpfung, Schlafstörungen, Libidoverlust oder chronische Beschwerden auftreten, greifen viele zu schnellen Lösungen.
Hier setzt die Naturheilkunde für Männer an: Sie bietet nachhaltige, sanfte Wege zur Wiederherstellung der Balance – körperlich, emotional und mental.
Männer stehen oft unter besonderem gesellschaftlichen Druck. Beruflicher Erfolg, Familie, Fitness – viele Aufgaben, die mit Energie und Durchhaltevermögen verbunden sind. Doch wenn Symptome wie Erschöpfung, Schlafstörungen, Libidoverlust oder chronische Beschwerden auftreten, greifen viele zu schnellen Lösungen.
Hier setzt die Naturheilkunde für Männer an: Sie bietet nachhaltige, sanfte Wege zur Wiederherstellung der Balance – körperlich, emotional und mental.